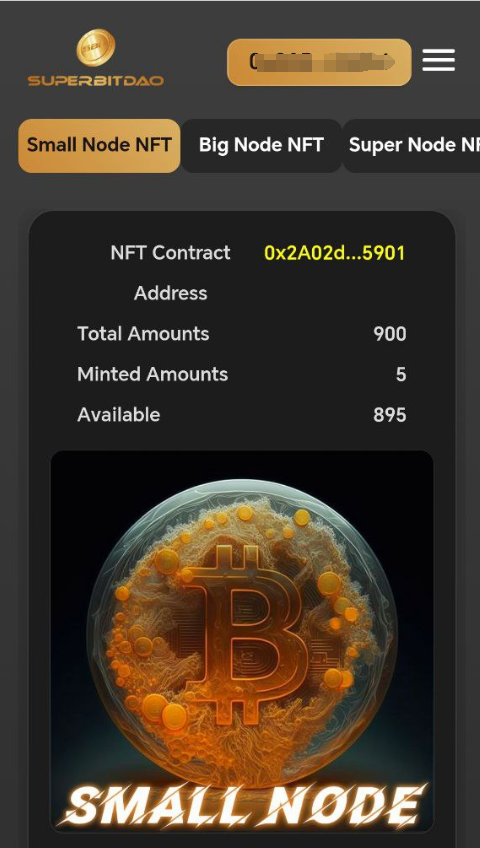
SuperBitDAO's tweet image. 🌟 Community users, you can now kickstart the Node NFT minting process, adding a new sparkle to our ecosystem. Take action now and experience the charm of super nodes! #SuperBitDAO #NodeNFT 🎉💎

#nodenft search results
The fact that #nodeNFT are really getting to the forefront makes everything seamlessly blissful, I intend to sacrifice my @seekers_xyz to the @GodsnGoblins pledging my allegiance to the Queen & gaining every reward attached to it. A good time to #FollowThePath ⚔️⚡Join the pledge

@sylo possesses the needed qualities to excel in the cryptoverse whilst ensuring that decentralized comm. is a reality via its #nodeNFT, @seekers_xyz. So far, its years of developing its comms capabilities has amassed partners, @flufworld, @ATEMCarClub, @futureverse, and more.💯

The recent move to the underground and preview of how the root network testnet interacts with @seekers_xyz by @aaronmcdnz has increased my excitement about the potential incentives for #Staking nodes using $SYLO and #nodeNFT hence aiming towards #Decentralization in communication

🌟 Community users, you can now kickstart the Node NFT minting process, adding a new sparkle to our ecosystem. Take action now and experience the charm of super nodes! #SuperBitDAO #NodeNFT 🎉💎
7. Additionally, for the past months, #nodeNFT have held live stream sessions on how to use your Seekers #3D #Assets. More so, @flufworld ran an #NFTGiveaways 🐰 made up of @mntge_io + @seanwotherspoon #Collections drops!, where one stood a chance to WIN 1x Fluf & 1x MNTGE Pass.

#onchain #Data #NodeNFT 💥Chain Guardians💥 @ChainStatsPro
It's unfortunate that 90% of mainstream crypto likely has 0 clue on what @ChainStatsPro does. Chain Guardians hold the key to unlocking $STATS! Own 75K $STATS and you're primed for #NODE action. Oh, and did I mention the #utilityNFT? It's your VIP pass to Validator paradise!

@sylo is leveraging their expertise to build a cutting-edge comm. layer of the @futureverse. Not to mention that their #nodeNFT is also making waves in terms of sales coupled with other #NFT Projects in the open Metaverse doing same opensea.io/assets/ethereu… opensea.io/assets/ethereu…
Dear #Sendinator! Are you as excited as we are for the Node NFT Presale this Friday? 🎉 Check it out at app.wesendit.io/nodes. Wishing you a fantastic start to the week! 😊 #NodeNFT #Presale #WeSendit
I'm opting to safeguard my @seekers_xyz & working collectively towards greater achievements is the choice I make to #ProtectOurFuture of the third world kingdom. Let us reject the path that'd lead us astray & prioritize the preservation of our #nodeNFT. 💡
What NOT to do if you want to save your Seekers! 😳 We must stay strong and stick together! #ResistThePath #SaveOurSeekers
Recently, I TP on $SYLO and if I come across any spare cash, I plan to place a buy order at a specific price point based on TA. I intend to allocate 60% of the funds, while the remaining will be distributed among #nodeNFT, hopefully an Ultra feat & Buzzies opensea.io/assets/ethereu…
The #nodeNFT innovation is one of the top developments for @sylo and users look forward to its implementation, where @seekers_xyz #NFTs would be used to run #nodes on the decentralized communication platform with users earning incentives 📈💰

It has to be a name that depicts the traits and culture of the #nodeNFT. Asking the #community for suggestions is one way to show the true inclusiveness of the ecosystem. Besides, the Hive or Bunker is quite great for me.🤑😎
Fluf World has the Underground, and our friends at Altered State Machine have the Cortex…. But what is the name for the Seeker dashboard? We are asking the community for submissions for names for the Seekers hub! So what shall it be? 🤔 forms.gle/uVGzYVavQziXbQ…

I could just imagine such glowing eyes searching painstakingly and moving through unit 177. Something is definitely in the works for a big reveal. Fingers crossed!📈🤑 #nodeNFT #Web3
The resilient survival of the Irradiated Buzzies in the face of such harsh and toxic conditions is a mystery. Despite the overwhelming odds against them, they managed to adapt and thrive in Unit 177. Can you hear that buzzing? 🐝 #FLUFWorld #PartyBear #Buzzies
Listed for 10500 , i have claimed the 12 month lump sum of $XDC (600 XDC) If you still want to purchase this #NodeNFT this is the price 💯 Next claim is the first week of July , 50 $XDC per month , forever.
I bought some $SYLO and it did a steady uptrend, I'm just excited to buy more when I've gotten more stables besides I'm in for the user centricity. #Web3 #nodeNFT 🙌😁
User interest right now: 1. $FIS 2. $BRKL 3. $AUDIO 4. $JOE 5. $SYLO 6. $ATRI 7. $HFT 8. $SLRS 9. $USDT 10. $CQT crypto-crash.com/index.php?sect…
opensea.io/assets/ethereu… Something to flaunt about; besides, @GodsnGoblins amulets were captivating, making me want to sacrifice my void @seekers_xyz, but then I choose to hodl, and soon enough since the @iamrootnetwork #blockchain is up and running, #nodeNFT staking would be next
The allure of this bronze amulet is so strong that it can drive individuals to #sacrifice their @seekers_xyz. The rarity of this mythical mineral gives a sense of optimism. Rather than succumbing to temptation, prioritize the well-being of your #nodeNFT & choose a different path.
Our bronze Amulets are forged using Verdine, an emerald green substance that seeps from the Dead Tree once every century. The rare sign of life from the decaying bark inspires hope in our kind, with multiple rituals & ceremonies surrounding this mythical mineral. #FollowThePath
opensea.io/assets/ethereu… The reality is that NFTs like Buzzies, @partybear, @flufworld, and @seekers_xyz are seeing high demand as people secure their position ahead of the upcoming #RootNetwork mainnet release, I also plan to use my #nodeNFT for the incentivized node #Staking.📈
🔥 MARKETPLACE UPDATE 🔥 We are excited to share the sneak-peek of the #NodeNFT marketplace 🥳 The dev team is sorting out the final touches before it goes live 💪 Stay tuned for the launch update! 🔥 #DeCloud #AVAX #MATIC #StackOS #NFT




1400 Deployments 🚀 Since the #NodeNFT launch on Sunday, over 700 apps have been deployed on our #DeCloud taking the total deployment number to 1400! 🔥 #StackOS community members got a chance to deploy an app themselves and experience true innovation! ✨ #DeployOnStackOS
Did you know that StackOS is THE MOST utilized decentralized cloud with 20 MILLION external service calls! #NodeNFT + Great utilization = True unstoppability

This is just the beginning. @DeployOnStackOS intends to provide compute for every single computer technology out there. They will run the world. *goosebumps* 😨 #DeCloud #NodeNFT #web3

We have got to admit it, these #NodeNFT designs are really awesome! The colours, the background, the lighting. Everything adds up to a pretty cool #NFT ownership experience. Excited about the launch! 🚀


🚨#StackOS PSA🚨 StackOS Single Token Staking program will be ending on March 30th. Unstake and claim all your $STACK rewards soon on governance.stackos.io All resources from there will now be used for the #NodeNFT program 🚀 ✅ Article: tinyurl.com/2vhspm69

8. ...and Burndown by @ATEMCarClub. Additionally, it will be utilized in the creation of avatars in @flufworld and @partybear, allowing for the incorporation of #Artificial_Intelligence. More collaborations are seen with @seekers_xyz, a #nodeNFT that aids in bootstrapping comm...

The recent move to the underground and preview of how the root network testnet interacts with @seekers_xyz by @aaronmcdnz has increased my excitement about the potential incentives for #Staking nodes using $SYLO and #nodeNFT hence aiming towards #Decentralization in communication

The fact that #nodeNFT are really getting to the forefront makes everything seamlessly blissful, I intend to sacrifice my @seekers_xyz to the @GodsnGoblins pledging my allegiance to the Queen & gaining every reward attached to it. A good time to #FollowThePath ⚔️⚡Join the pledge

🚨MINTING IS NOW LIVE!🚨 Gen1+ #NodeNFT minting is now live! 🚀 Head on to mint.stackos.io to start minting the #NFTs and be a part of the most innovative #node program! 🔥 #DeCloud #StackOS

@sylo possesses the needed qualities to excel in the cryptoverse whilst ensuring that decentralized comm. is a reality via its #nodeNFT, @seekers_xyz. So far, its years of developing its comms capabilities has amassed partners, @flufworld, @ATEMCarClub, @futureverse, and more.💯

7. Additionally, for the past months, #nodeNFT have held live stream sessions on how to use your Seekers #3D #Assets. More so, @flufworld ran an #NFTGiveaways 🐰 made up of @mntge_io + @seanwotherspoon #Collections drops!, where one stood a chance to WIN 1x Fluf & 1x MNTGE Pass.

Here are some infos about @unicornnodes: 🦄Whitelist, Public Pre-sale and launch🦄: | WL Pre-sale: Price: $6 | Public Pre-sale: Price: $10 | Pre-Seed Sale Price: $12 (Max 4,166 tokens) SOLD OUT! | Launch price will be $2 Don't miss it! #NodeNFT #passiveincome #Whitelist

Something went wrong.
Something went wrong.
United States Trends
- 1. National Guard 87.3K posts
- 2. Thanksgiving 416K posts
- 3. #InfoSecVPN N/A
- 4. Frank Ragnow 2,914 posts
- 5. Bayern 162K posts
- 6. D.C. 214K posts
- 7. Mbappe 85.2K posts
- 8. Arsenal 289K posts
- 9. Kimmich 5,342 posts
- 10. Patrick Morrisey 1,524 posts
- 11. Denzel 4,203 posts
- 12. Lennart Karl 5,937 posts
- 13. Olympiacos 19.7K posts
- 14. Anthony Rendon N/A
- 15. Golesh 3,138 posts
- 16. Wine 39.8K posts
- 17. Pizza 47.3K posts
- 18. #ARSBAY 4,038 posts
- 19. Jennifer Griffin N/A
- 20. Fani Willis 23.2K posts















































